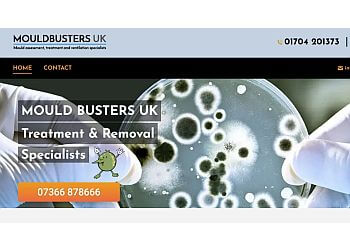
Southport Website Design

Speciality:
“Southport Website Design specialises in new business startups, E-commerce websites and Social media. Their mission is to make it work and look great at the same time. They use the latest multi-device software to deliver lightning-fast speeds. They provide professionally designed, unique websites tailored to your business needs. Southport Website Design also creates a responsive website so that your web pages are compatible with any device. For every website they create, text and images will be optimised on the page so that search engines can find you with your corresponding services. They offer Web Design, Business Email and Website Hosting. Southport Website Design provides free domain names for every web design.
2025 Update: They offer an initial consultation. They accept Visa, Mastercard and American Express payments.”